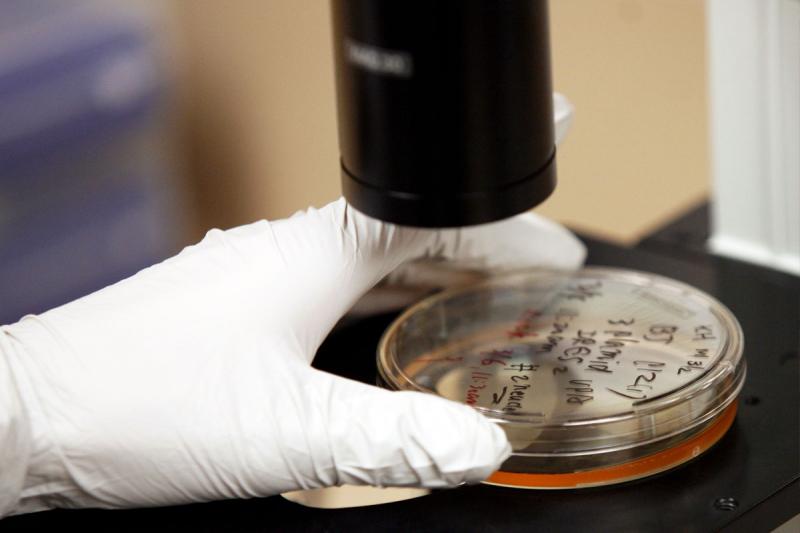
1602-02557066461

El Reino Unido concedió ayer su primera autorización para modificar genéticamente embriones humanos con fines de investigación, un proyecto que da esperanzas a las parejas con problemas reproductivos pero que genera inquietudes éticas.
La autoridad británica de Fertilización Humana y Embriología, la HFEA anunció que permitirá la utilización del método Crispr-Cas9, que permite centrarse en los genes defectuosos para neutralizarlos de manera más precisa.
Se trata de una de las primeras autorizaciones en el mundo para la manipulación de embriones humanos.
Es un poco como “un tratamiento de textos que permite editar o corregir la tipografía de un documento”, explicó a la AFP la bióloga francesa Emmanuelle Charpentier, que desarrolló la técnica junto a la estadounidense Jennifer Doudna.
La técnica ya ha sido utilizada por numerosos científicos que intentan encontrar tratamientos contra el cáncer y otras enfermedades. Pero al mismo tiempo suscita preocupación en su aplicación a células reproductoras y a embriones humanos.
“Nuestro comité ha aprobado la solicitud de la doctora Kathy Niakan, del Francis Crick Institute (de Londres), para renovar su licencia de investigación en laboratorio, añadiendo la posibilidad de edición (manipulación) genética de embriones”, indicó la HFEA en un comunicado.
La solicitud fue presentada el mes de septiembre para estudiar los genes que intervienen en el desarrollo de células que van a formar la placenta.


